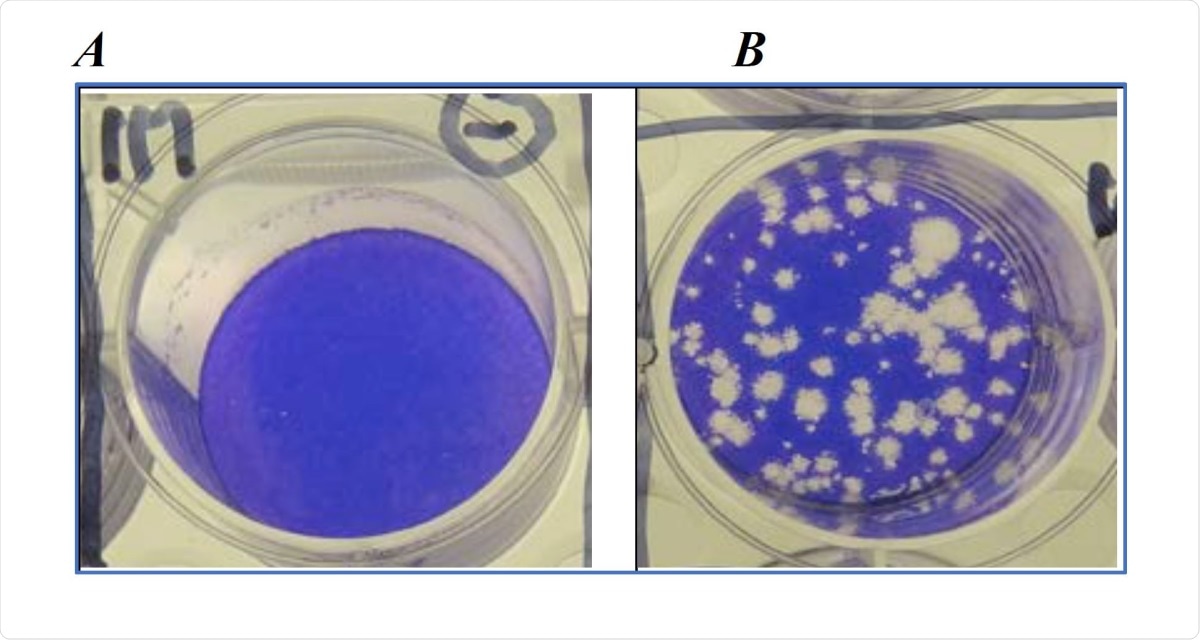
Plaque Assay with SARS-CoV-2. A) uninfected VERO-E6 cells grown to confluency and stained with crystal violet to show take up by viable cells. B) confluent VERO-E6 cells infected with SARS-CoV-2 and subsequently stained with crystal violet to show dead and dying cells seen as clear plaques.

The coronavirus disease 2019 (COVID-19), caused by the severe acute respiratory syndrome coronavirus 2 (SARS-CoV-2) pathogen, continues to spread worldwide, with many countries reporting surging cases. The virus spreads primarily through respiratory droplets and aerosols that hang in the air after an infected person coughs, sneezes, breathes, or speaks.
These droplets can also spread through contaminating surfaces that are commonly touched (also known as ‘fomites’), such as doorknobs, tables, stair rails, and telephone handles, to name a few.
A new study by researchers at the University of Southampton, UK, has found that SARS-CoV-2 can inactivate on copper surfaces in as little as 1 minute. This is faster than the findings of previous studies in which it took as much as 4 hours before the virus was inactivated.

 *Important notice: bioRxiv publishes preliminary scientific reports that are not peer-reviewed and, therefore, should not be regarded as conclusive, guide clinical practice/health-related behavior, or treated as established information.
*Important notice: bioRxiv publishes preliminary scientific reports that are not peer-reviewed and, therefore, should not be regarded as conclusive, guide clinical practice/health-related behavior, or treated as established information.
Copper as an antiviral agent
Copper has inherent antimicrobial qualities. When cleaned properly and regularly, commonly touched surfaces with uncoated copper alloy materials will effectively kill infectious pathogens.
In different forms, copper has been widely used in research and clinical settings to reduce the risk of bacterial and viral contamination. Hence, many studies have explored the use of copper surfaces and materials to combat the spreading of SARS-CoV-2.
The United States Environmental Protection Agency (EPA) reports that antimicrobial copper alloys are intended for the manufacture of touch surface components used in hospitals, laboratories, healthcare facilities, and other public, commercial, and residential buildings.
But how does copper inactivate viruses? Copper destroys the replication and propagation abilities of viruses, such as SARS-CoV-2, influenza, and other respiratory viruses. Further, copper can eradicate pathogenic organisms such as coronavirus, influenza, human immunodeficiency virus (HIV), and fungi after a short period of exposure.
The study
The study, published on the preprint bioRxiv* server, showed that copper is a potent antiviral metal, that can cause rapid inactivation of pathogens on touch surfaces in just minutes. The team confirmed that the metal inactivated SARS-CoV-2 in as little as 1 minute.
In a past study by the researchers, they have shown that the human coronavirus 229E (Hu-CoV-229E), the virus that causes common colds, survives for more than five days on inanimate surfaces like glass, metal, and plastics. In the study, they showed the rapid inactivation of the virus within 10 minutes on various copper surfaces.
Another study, which was one of the first to show that SARS-CoV-2 can survive many days on inanimate objects, indicated that copper took 4 hours to inactivate SARS-CoV-2. To explore the antiviral potential of copper further, the team repeated their previous work on SARS-CoV-2.
The researchers used metal coupons, including copper and stainless steel. From there, the team has spread infected cell supernatant preparations of SARS-CoV-2 over the meta coupons, 1 µl to simulate hand transfer or 10 µl to simulate respiratory droplet contact, and incubated at room temperature.
The team removed the virus from the test surfaces after various time points using an infection medium and assayed for infectious virus survival using a plaque assay.
Plaque Assay with SARS-CoV-2. A) uninfected VERO-E6 cells grown to confluency and stained with crystal violet to show take up by viable cells. B) confluent VERO-E6 cells infected with SARS-CoV-2 and subsequently stained with crystal violet to show dead and dying cells seen as clear plaques.
As little as one minute
The researchers found that there was no viable virus recovered from the copper or copper-coated stainless steel after 1 minute of exposure for metal coupons with 1 µl inoculum to simulate hand transfer.
Using a 10 µl inoculum to simulate respiratory droplet contact, this took over 10 minutes to dry when incubated at room temperature.
The team, however, noted that replacing existing metal surfaces with copper material is expensive. The team suggests that coating existing metal and plastic surfaces with copper may be a cheaper and cost-effective method to have a self-disinfecting surface.
Though it might be late to install these surfaces amid the pandemic, it can help in future viral outbreaks. It also has potential use in healthcare settings and other public areas where transmission is thought to be high, like hospitals and public transport.
Installing potent antimicrobial copper alloys and coatings into healthcare and public transport systems offers a simple defense in the fight to delay the spread of future pandemic diseases until vaccines become available,” the researchers wrote in the paper.
To date, the number of infected individuals has reached 85.67 million, and the virus has claimed over 1.85 million lives worldwide. The United States reports the highest case and death tolls, with more than 20.81 million cases, and 353,000 deaths. Other countries with high COVID-19 cases include India, with more than 10.35 million cases, Brazil, with over 7.75 million cases, Russia, with more than 3.22 million cases, and the United Kingdom, with over 2.72 million cases.

 *Important notice: bioRxiv publishes preliminary scientific reports that are not peer-reviewed and, therefore, should not be regarded as conclusive, guide clinical practice/health-related behavior, or treated as established information.
*Important notice: bioRxiv publishes preliminary scientific reports that are not peer-reviewed and, therefore, should not be regarded as conclusive, guide clinical practice/health-related behavior, or treated as established information.
Source:
Journal reference: